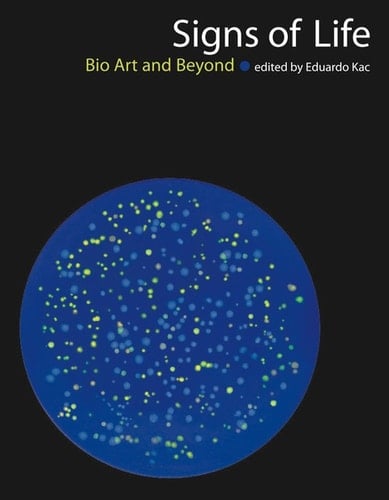
Signs of Life Joseph Von Fraunhofer and the Craft of Precision Optics

Bio art is a new art form that has emerged from the cultural impact and increasing accessibility of contemporary biotechnology. Signs of Life is the first book to focus exclusively on art that uses biotechnology as its medium, defining and discussing the theoretical and historical implications of bio art and offering examples of work by prominent artists. Bio art manipulates the processes of life; in its most radical form, it invents or transforms living organisms. It is not representational; bio art is in vivo. (A celebrated example is Eduardo Kac's own GFP Bunny, centered on ""Alba, "" the tr.
Page Count:
433
Publication Date:
2016-01-01
ISBN-10:
0262311615
ISBN-13:
9780262311618
No comments yet. Be the first to share your thoughts!